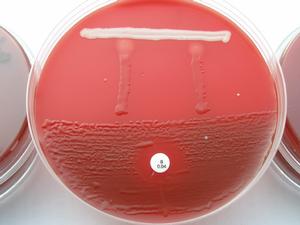
氣性壞疽

氣性壞疽
氣性壞疽 致病菌
 氣性壞疽
氣性壞疽 梭狀芽胞桿菌廣泛存在於泥土和人畜糞便中,所以易進入傷口,但並不一定致病。氣性壞疽的發生,並不單純地決定於氣性壞疽桿菌的存在,而更決定於人體抵抗力和傷口的情況,即需要一個利於氣性壞疽桿菌生長繁殖的缺氧環境。因此,失水、大量失血或休克,而又有傷口大片組織壞死、深層肌肉損毀,尤其是大腿和臀部損傷,彈片存留、開放性骨折或伴有主要血管損傷,使用止血帶時間過長等,容易發生氣性壞疽。
發病機理
 梭狀芽孢桿菌
梭狀芽孢桿菌 臨床表現
潛伏期可短至6~8h,但一般為1~4天。
 氣性壞疽
氣性壞疽 早期病人表情淡漠,有頭暈、頭痛、噁心、嘔吐、出冷汗、煩躁不安、高熱、脈搏快速(100~120次/min),呼吸迫促,並有進行性貧血。晚期有嚴重中毒症狀,血壓下降,最後出現黃疸、譫妄和昏迷。
局部表現
病人自覺患部沉重,有包紮過緊感。以後,突然出現患部“脹裂樣”劇痛,不能用一般止痛劑緩解。患部腫脹明顯,壓痛劇烈。傷口周圍皮膚水腫、緊張,蒼白、發亮,很快變為紫紅色,進而變為紫黑色,並出現大小不等的水泡。傷口內肌肉由於壞死,呈暗紅色或土灰色,失去彈性,刀割時不收縮,也不出血,猶如煮熟的肉。傷口周圍常捫到捻發音,表示組織間有氣體存在。輕輕擠壓患部,常有氣泡從傷口逸出,並有稀薄、惡臭的漿液樣血性分泌物流出。
診斷
細菌培養
細菌培養 診斷主要依據臨床表現、傷口分泌物檢查和X線檢查,如損傷或手術後,傷口出現不尋常的疼痛,局部腫脹迅速加劇,傷口周圍皮膚有捻發音,並有嚴重的全身中毒症狀,如脈搏加速、煩躁不安進行性貧血,即應考慮有氣性壞疽的可能;傷口內的分泌物塗片檢查有大量革蘭染色陽性桿菌,X線檢查傷口肌群間有氣體,是診斷氣性壞疽的三個重要依據。
厭氧細菌培養和病理活檢雖可肯定診斷,但需一定時間,故不能等待其結果,以免延誤治療。
鑑別診斷
 蜂窩織炎
蜂窩織炎 (2)厭氧性鏈球菌性蜂窩織炎 發病較緩慢,往往在傷後3天才出現症狀。毒血症、疼痛、局部腫脹和皮膚改變均較輕。有氣腫和捻發音出現,但氣腫僅局限於皮下組織和筋膜。傷口周圍有一般的炎性表現。滲出液呈漿液膿性,塗片檢查有鏈球菌。
(3)大腸桿菌性蜂窩織炎 可出現組織間氣腫,且有高熱和譫妄等毒血症狀。但局部腫脹發展較慢,膿液具有大腸桿菌感染的膿液特徵,即膿液稀薄,呈漿液性。膿液塗片檢查可發現革蘭染色陰性桿菌。
治療措施
氣性壞疽發展迅速,如不及時處理,病人常喪失肢體,甚至死亡。故一旦確診,應立即積極治療。
 截肢術
截肢術 (1)立即積極治療,嚴格 隔離,加強護理,嚴防交叉感染。
(2)清創引流,切口必須充分,用大量3%雙氧水沖洗,傷口徹底開放。肢體廣泛壞死者應行 截肢術,以挽救生命。
(3)大量套用 抗生素。
(4)高壓氧治療,可在3個大氣壓的純氧下進行治療,第一天3次,每次2—4小時,以後每天2次。
(5)全身支援治療。
(6)中藥治療。
用藥原則
術前、術中和術後肌肉或靜滴大劑量抗生素往往以青黴素G為首選,毒血症和局部情況好轉後減量套用,如青酶素過敏可改用紅酶素,必要時可選用先鋒酶素,先鋒必等頭孢類抗生素。通過藥敏選擇抗生素。同時認真糾正水、電解質平衡及酸、鹼平衡,大量維生素,能量合劑。每次輸入新鮮血,給予高蛋白,高熱量飲食,加強支援療法。
緊急手術處理
在搶救嚴重休克或其他嚴重併發症的同時,須緊急進行局部手術處理,手術前靜脈滴注青黴素200萬U和四環素0.5g。一般應採用全身麻醉,不用止血帶。術中應注意給氧,繼續輸血,輸液和套用抗生素。在病變區作廣泛、多處切開(包括傷口及其周圍水腫或皮下氣腫區),切除已無生活力的肌組織,直到具有正常顏色、彈性和能流出新
 高壓氧艙
高壓氧艙 有下列情況者應考慮截肢:a、傷肢各層組織均已受累且發展迅速;b、肢體損傷嚴重,合併粉碎性開放骨折或伴大血管損傷;c、經清創處理感染仍不能控制,有嚴重毒血症者。截肢部位應在肌肉未受累的健康組織處。截肢殘端不縫合,用過氧化氫液濕敷,待傷口癒合後再修整。
高壓氧療法
在3個大氣壓純氧下,以物理狀態溶解在血內的氧比平時增加20倍左右,可提高組織的氧含量,抑制氣性壞疽桿菌
 靜脈滴注
靜脈滴注 抗生素治療
大劑量使用青黴素(1000萬U/d)和四環素(2g/d),兼可控制化膿性感染,減少傷處因其他細菌繁殖消耗氧氣所造成的缺氧環境。待毒血症狀和局部情況好轉後,即可減少劑量或停用。對青黴素過敏者,可改用紅黴素,1.5~1.8g/d,靜脈滴注。
全身支持療法
少量多次輸血,糾正水與電解質代謝失調,給予高蛋白、高熱量飲食,止痛、鎮靜、退熱等。
氣性壞疽抗毒血清對氣性壞疽的防治效果不佳,僅能起到暫時緩解毒血症的作用,而且還有使病人發生過敏反應的危險,現已很少套用。
療效評價
(1)治癒:全身和局部症狀消失,傷口基本癒合。
(2)好轉:截去某一肢體,全身症狀改善。
(3)未愈:全身中毒症狀加重,多器官功能衰竭。
預防
徹底清創是預防創傷後發生氣性壞疽的最可靠方法。在傷後6h內清創,幾乎可完全防止氣性壞疽的發生。即使受
 開放引流
開放引流 對疑有氣性壞疽的傷口,可用3%過氧化氫或 1:1000高錳酸鉀等溶液沖洗、濕敷;對已縫合的傷口,應將縫線拆去,敞開傷口。青黴素和四環素族抗菌素在預防氣性壞疽方面有較好的作用,可根據創傷情況在清創前後套用。但不能代替清創術。
應將病人隔離,病人用過的一切衣物、敷料、器材均應單獨收集,進行消毒。煮沸消毒應在1h以上,最好用高壓蒸氣滅菌,換下的敷料應行銷毀,以防交叉感染。
參考資料
1. http://jbk.39.net/keshi/crk/490aa.html
2. http://www.china.com.cn/health/txt/2008-05/20/content_15356832.htm
3. http://www.120top.cn/pub/200712/11969320593.htm
4. http://ask.39.net/browse/1059-1-1.html

